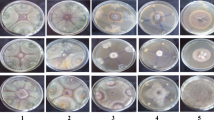

Abstract
Yellowing and wilting of black pepper vines is a serious concern in many black pepper growing tracts where Pythium deliense was recently emerged as a pathogen from the rhizosphere of affected vines, which is proved to be pathogenic by Koch’s postulates. As a measure to manage the symptoms, bioagents were evaluated against infection by P. deliense. Among the seven bioagents tested, Trichoderma harzianum and Streptomyces albulus showed 100% inhibition in vitro followed by one Streptomyces sp. and S. rimosus (75.33%). The potential ones were further evaluated under the hydroponic system in vivo by challenge inoculation. No root infection was noticed with T. harzianum and S. albulus inoculation, instead, the inoculated plants showed root regeneration. This suggests the efficiency of these bioagents on plant growth promotion as well as on disease suppression. Biochemical analysis of the hydroponic medium showed an increase in membrane conductivity in all the treatments except in T. harzianum. The release of phenolic compounds into the medium was lowest with T. harzianum indicating the prevention of pathogen invasion. In planta evaluation under greenhouse condition and field evaluation also showed the protective effect of T. harzianum and S. albulus with a reduction in the intensity of yellowing to an extent of 73.1% and 71.2%, respectively. The study revealed that T. harzianum and the actinomycete S. albulus had the potential to prevent the root rot caused by P. deliense.
Similar content being viewed by others
Avoid common mistakes on your manuscript.
Introduction
Black pepper (Piper nigrum L.) the ‘King’ among the spices, is an important commodity in the global market. Until 2001, India was the leading producer of black pepper in the world, but currently, India stands at the 3rd position. This gradual decrease in production is generally due to biotic and abiotic stresses. Black pepper is susceptible to several diseases triggered by bacteria, fungi, Oomycete, viruses, phytoplasma besides nutritional disorders. Among the maladies, foot rot due to Phytophthora capsici, slow decline due to combined infection of P. capsici and nematodes are major concern (Anandaraj and Sarma 1995; Bhai et al. 2017). In 1998, Matsuda et al., isolated Pythium deliense as a week pathogen in their study on the root disease of black pepper accompanied by yellowing and wilting symptoms caused by P. splendens. Truong et al. (2005), isolated Pythium spp. along with Phytophthora and Fusarium from the diseased root tissues and soil samples during the survey of quick wilt of black pepper in Vietnam and they proved pathogenicity of Pythium on 6-month-old black pepper vines. Association of Pythium spp. with yellowing and wilt of black pepper, predominantly during the post-monsoon season was a new observation. Pythium deliense Meurs was isolated and identified from the affected black pepper during 2017 (Subila and Suseela 2020). Once P. deliense infects the roots, the entire root system will be damaged and results in yellowing, wilting, and finally drying up of the vines leading to severe crop loss. The seriousness was realized only recently and so, as such, there is no strategy available for the management of the disease. The application of bioagents is an alternative eco-friendly strategy for managing P. deliense infections. Since eco-friendly management strategies are the current trend in disease management strategies, biocontrol agents become alternatives to hazardous chemicals.
Biocontrol agents are natural occupants of the rhizosphere and can protect the plants without harming the environment. They improve soil fertility and thereby enhancing the plant growth besides protecting the plants from deleterious microbes (Itelima et al. 2018). Several microorganisms such as bacteria, fungi, and actinomycetes are being used as biocontrol agents against many plant pathogens world over. Biocontrol of plant diseases, particularly of fungal origin, has been attained using microbes such as Trichoderma sp., Pseudomonas sp., Bacillus sp., and Streptomyces sp., etc. (Elad et al. 1980; Ligon et al. 2000; Raaijmakers et al. 2002; Trejo-Estrada et al. 1998). The potential of Trichoderma in combating soil-borne pathogens has been demonstrated more than 8 decades ago (Weindling 1934) and at present, it is the most extensively used biocontrol agent (Mukherjee et al. 2012).
Similarly, Actinomycetes are well known for the production of antibiotics and it plays a significant role in combating various plant pathogens (Bressan 2003; Chamberlain and Crawford 1999; Doumbou et al. 2001a; Trejo-Estrada et al. 1998; Yuan and Crawford 1995; Bhai et al. 2016; Anusree et al. 2019) and colonizes in the rhizoplane and rhizosphere thereby it is qualitatively and quantitatively important and is used as an ideal tool for biocontrol-mediated disease management (Weller 1988; Crawford et al. 1993; Doumbou et al. 2001b; Tokala et al. 2002). Streptomyces spp. has been recognized as the most significant producer of bioactive metabolites which are known to possess antibacterial, antifungal, antioxidant, anti-cancer, anti-algal, anti-helminthic, anti-malarial and anti-inflammatory properties (Kekuda et al. 2010; Ravi kumar et al. 2012). Therefore, the objective of the present study was to elucidate the mechanism and biocontrol efficacy of T. harzianum and Streptomyces species to manage yellowing and wilting of black pepper associated with P. deliense infections.
Materials and methods
Biocontrol agents
Trichoderma harzianum strain MTCC5179 and six isolates of Actinomycetes viz. Streptomyces albulus strain IISR BP Act1 (Acc. No. KM361516), Kitasatospora setae strain IISR Act2 (Acc. No.KC619536), Streptomyces sp. strain IISR Act5 (Acc. No. KU315555), S. tauricus strain IISR Act9 (Acc. No. KU359415), S. rimosus strain IISR BP Act25 (Acc. No. KM361514) and S. olivaceiscleroticus strain IISR BP Act42 (Acc. No. KM361515), were collected from the repository of beneficial isolates at ICAR-IISR, Kozhikode. These strains of Actinomycetes were molecularly identified by 16S rDNA sequencing using specific primers S-C-Act-235-S-20 & S-C-Act-878-A-19 and 27f & 1525r, and based on morphological characterization such as colony morphology, spore chain morphology and spore surface morphology (Anusree 2019). T. harzianum and Actinomycetes used in this study were previously characterized for the production of hydrolytic enzymes such as cellulase, amylase, siderophore and growth-promoting metabolites such as indole 3-acetic acid, HCN, NH3, etc. and have inhibitory activity towards plant pathogens such as Phytophthora capsici, Sclerotium rolfsii, Rhizactonia solani, Fusarium oxysporum and Colletotrichum gleosporidiosis (Bhai et al. 2016; Thampi and Bhai 2017).
Pathogen
Pythium deliense strain IISR BPPY Mp2 (Acc. No. MH017856) used in this experiment was isolated from the rhizosphere of yellowing affected black pepper (Kozhikode, Kerala—76.0878° E and 11.4438° N). P. deliense was characterized with floral cottony mycelium with simple filamentous inflated/torulated sporangia. This strain was a fast-growing oomycete with smooth oogonia and bending of oogonial stalks towards the antheridia, typical characteristic of P. deliense. It can grow at a pH range from 4.5 to 10 and at a temperature range of 15–40 °C (Subila and Suseela 2020).
In vitro assay
Dual plate assay described by Hazarika (1998) was adopted to check the direct inhibition of potential of isolates against P. deliense. Actinomycetes were streak cultured on the Potato Dextrose Agar plate as two lines equidistant from the edge of the plate and mycelial plug of 72-h-old culture of P.deliense was placed in the center and incubated at 30 °C for 72 h. Mycelial plugs of T. harzianum and P.deliense placed in a single plate equidistant from the edge of the plate on the opposite side and incubated. P. deliense inoculated of the plate served as Control. The percentage inhibition of the pathogen was calculated using the formula.
I = (C − T)/C × 100 (Vincent 1947) where I is the percent inhibition, C is the radial growth in control plate, T is the radial growth of the pathogen in bioagent inoculated plate. Isolates showing more than 75% inhibition were shortlisted for further studies.
In vivo study under hydroponic system
To study, the plant physiological changes and the interaction of biocontrol agents with the pathogen as well as with plants, a hydroponic experiment was conducted, in which the plants were uprooted and placed in sterile distilled water (100 ml) in bottles after thoroughly cleaning the roots to remove soil debris. Bio agents were added to this at the rate of 108 CFU/ml. After 3 days, five numbers of inoculum plugs (5 mm diameter) cut from 72 h old culture of P. deliense were inoculated to the plants and incubated for 20 days. Control with bioagents individually, pathogen alone, and an absolute control with plants alone were also kept. Conductivity, production of total phenol, OD phenol, and polyphenol in the hydroponic solution and the changes in the plant physiology were recorded periodically with distilled water as control (Vandana et al. 2014).
In planta greenhouse evaluation
A pot experiment was conducted under greenhouse conditions to confirm the efficacy of the biocontrol agents against the pathogen in planta. Rooted plants of 3–4 leaf stage of var. Panniyur 1 was transplanted in plastic pots containing 500 g solarized potting mixture. The pathogen, P. deliense in the form of macerated broth culture @ 105 CFU/ml (Bhai et al. 2005) was inoculated after 15 days of the establishment of the plants. Observations were recorded on disease incidence and Disease Potential Index of the soil.
Field evaluation
Experimental plot
Field evaluation of the promising bioagents was carried out in a 5-year-old Panniyur-1 black pepper plot at Ambalavayal (76.2103° E, 11.6197° N), Wayanad, Kerala, where the incidence of yellowing in black pepper was most prevalent. The study was conducted during 2018–2019, starting from the post-monsoon season of 2018. Selected a portion of the uniformly infected plot for the experiment and each vine was indexed visually for the intensity of yellowing using a 0–4 scale.
Experimental treatments
There are four treatments (i) T. harzianum (MTCC 5179), (ii) S. albulus (IISR BP Act1), (iii) a chemical control (Metalaxyl mancozeb @ 0.125%) and (iv) an absolute control without any treatment. Each treatment was conducted as five replications in a randomized block design. Spore suspension of T. harzianum was prepared and adjusted to a concentration of 108 spores/ml and S. albulus was mass multiplied in malt extract broth and a CFU of 108/ml was used for the treatment. The potential bioagents were applied @ 1L/vine as a soil drench and repeated at 2 months intervals for six times. Observations were recorded at monthly intervals on the intensity of yellowing, disease potential index, soil pH, conductivity, soil organic carbon, and introduced microbial load.
Statistical analysis
All lab experiments performed using three biological replicates within which each treatment includes three replicates. The data on the visual scoring of yellowing (0–4 scale) were converted to yellowing intensity (Eapen et al. 2009). SAS 9.0 software was used for the analysis of variance (ANOVA) to test the significance of the treatments. Duncan’s multiple range test (DMRT) was used to evaluate the values of significant treatment means at a 5% level of significance.
Results
In vitro assay
All the bioagents tested were showed more than 60% inhibition. However, T. harzianum and IISR BP Act1 inhibited the pathogen completely (100% inhibition) followed by IISR Act5 and IISR BP Act25 (75.33%). T. harzianum and IISR BP Act1 were found to overgrow the pathogen completely after 5 days of incubation (Fig. 1). All other isolates showed less than 75% inhibition (Table 1). Therefore, these four bioagents were shortlisted for further evaluation.
In vivo study-hydroponic system
On pathogen infection, plants will try to defend themselves against the pathogen by releasing compounds like phenols. As infection progresses damage of cell membrane occurs and leads to the release of high amount of phenolics to the medium (Fig. 2). In this in vivo experiment, initially the root tips were infected in the pathogen control and further leads to root rot and release of phenolic compounds to the medium causing formation of brown colour in the medium but in case of bioagents no root infection and brown colouration were noticed. The amount of total phenol and OD phenol content in the solution showed a declining trend from 12th day onwards with T. harzianum whereas a decrease in the amount of OD phenol was noticed from 15th day onwards with IISR BPAct1. In the case of IISR Act5 and IISR BP Act25 the amount of total phenol in the solution was increasing from 0.7 to 9.1 µg/ml. In pathogen control, total phenol was recorded as 0.3 to 13 µg/ml which is 18.85 times more than absolute control and OD phenol range from 1.8 to 10.5 µg/ml and it was 2.6-fold more than absolute control. In the case of polyphenol, with T. harzianum showed less release of polyphenol to the solution than other treatments. IISR BP Act 1 and IISR BP Act 25 showed maximum level only up to 7.3 µg/ml and IISR Act5 released 9.1 µg/ml, whereas in pathogen control, it was up to 22.0 µg/ml. Membrane conductivity showed an increasing trend in all the treatments except in T. harzianum (Table 2), also the plants were showing regeneration of new roots in treatment with T. harzianum (average of 9.7) followed by IISR BP Act1 (average of 4) thus revealing the efficiency of these bioagents in growth promotion and suppression of pathogens.
In planta green house evaluation
In planta evaluation under greenhouse condition revealed that T. harzianum and IISR BPAct1 have the potential to completely inhibit the root rot caused by P. deliense. No visible symptoms or root infection was noticed in such plants even after 14 days or till the end of the experiment as seen in absolute control. In pathogen control, 100% root rot was noticed within 14 days of inoculation with collar rot and wilting, whereas defoliation was noticed in treatment with IISR BP Act25 (Fig. 3, Table 3).
Field evaluation
Treatments with T. harzianum and S. albulus strain IISR BP Act1 showed a decrease in the intensity of yellowing in comparison with control. The yellowing was reduced to more than 70% (73.1% and 71.2%) in treatments with T.harzianum and S. albulus (IISR BPAct1), respectively. In chemical treatment, it was only 32.5% (Table 4). Disease potential index was also reduced from 16 to 2 due to the activity of bioagents. Basic soil physiological characteristics such as pH, electrical conductivity, organic carbon, and microbial population were also analyzed. Soil pH was increasing with bioagent treatments and the population level of Trichoderma and Actinomycetes was also on the increase in the respective treatments (Table 5). The total number of bacteria increased from 105 to 107 in both T. harzianum and S. albulus treatments and is higher than in the control (105). Trichoderma and Actinomycete populations in the soil remain in the soil (Table 6). Soil organic carbon was also increased from 0.53 to 1.63% in the case of T. harzianum and from 0.52 to 1.93% with S. albulus (IISR BPAct1) thus indicating an improvement in the soil quality by the application of the bioagents.
Discussion
The investigation on the role of P. deliense in yellowing and further crop loss in black pepper leads to the necessity of an integrated management strategy, which can reduce the intensity of yellowing by controlling P. deliense as well. Biocontrol activity of Trichoderma and actinomycetes in combating black pepper disease was already reported (Bhai et al. 2016). Bio agents showing more than 75% inhibitory activity in vitro were taken for in vivo and in planta evaluations and the results clearly showed that T. harzianum and S. albulus (IISR BPAct1) are effective in inhibiting the pathogen thereby reducing the intensity of yellowing. Under hydroponic system, it is hypothesized that plant–pathogen interaction would result in a colour change in the medium due to the exudation of phenolics by the rupture of the cell wall due to pathogen ingression. A positive plant–pathogen bioagent interaction would be the absence of coloration, where the bioagent prevents the pathogen from entering into the tissues. In our study also, in the hydroponic system, the release of phenolic compounds to the solution was lowest in the case of T. harzianum which indicates the defense mechanism exerted by T. harzianum against the pathogen by preventing the entry of the pathogen into the system followed by S. albulus. New roots were produced in the variety Panniyur 1, showing the plant growth-promoting efficiency of the bioagents. Field evaluation as well as greenhouse evaluation supports this finding that T. harzianum is effective against P. deliense and reveals the efficiency of the potential isolates in demolishing the effects of P. deliense. Field evaluation revealed that the biocontrol agents can reduce the intensity of yellowing and disease potential index of the pathogen in the soil and also the presence of biocontrol agents in the soil could increase the soil properties.
The excessive use of chemicals as pesticides to eradicate plant pathogens causes environmental pollution as well as makes the pathogens to become resistant to chemical pesticides. The toxicity of the chemicals and their accumulation in plants or soil has harmful effects on humans and the biosphere (Aboutorabi 2018). Use of biocontrol agents like T. harzianum and actinomycetes are considered as ecologically sustainable and safe crop protection solutions (Khare and Upadhyay 2009; Muthukumar et al. 2011). Extensive researches are being executed in the world to sustain and enhance the health of ecosystems and to confront fungicidal resistant pathogens. The value of the global biopesticide market is expected to reach $4556.37 Million by 2019, at a compound annual growth rate of 15.30% from 2014 to 2019. Such growth can be attained by the increasing concerns on the influence of residues and reckless use of synthetic chemical pesticides and the increasing importance of pests and pathogens, emergence of new invasive species, and pesticide-resistant strains of pests and also the effect of changing climatic conditions.
Enhancing resistance in plants is the most potent strategy to prevent biotic losses in crops. Beneficial microbes in the rhizosphere could induce systemic resistance in plants by enhancing the defensive capacity of the plant (Conrath et al. 2015). Trichoderma, the most studied mycoparasite vary in host range and produce structures for attachment on the pathogen and kill their hosts (pathogens) by producing cell wall degrading enzymes alone or in combination with antimicrobial secondary metabolites (Nygren et al. 2018). A synergistic transcription of various genes involved in cell wall degradation was also reported for Trichoderma atroviride in interaction with B. cinerea and Phytophthora capsici (Reithner et al. 2011). Benhamou and Chet (1997) reported that Trichoderma exhibit predatory behavior under nutrient-limited conditions. It produces a range of enzymes that are directed against cell walls of pathogenic fungi. For example, sometimes Trichoderma sp. does not directly attack the plant pathogen, whereas it produces chitinase to parasitize the pathogen in which the chitinase genes of Trichoderma sp. were activated by the decreased concentration of cellulose. Heydari and Pessarakali (2010) defined Trichoderma as a potential elicitor of plant host defenses. According to Lo et al. (1997) soil application of T. harzianum significantly reduced Pythium blight, root rot, and brown patch disease and also reduced the foliar phases of plant diseases by the spray application. T. harzianum strain can survive on plant phylloplane which is also a desirable trait for biocontrol agents against foliar pathogens. In the study of biological control of Pythium root rot in broccoli by El-Mohamedy (2012) reported that T. harzianum could successfully reduce P.ultimum (100%) by in vitro and 88% of disease reduction in pot experiment studies. Küçükyumuk et al. (2014), reported that the combined application of Zinc with G. intraradices could control the P. deliense induced seedling rot disease in cucumber under pot conditions. Therefore, our study also suggests that soil application of T. harzianum and S. albulus during post-monsoon season could be effectively used as a management strategy in reducing the intensity of yellowing in black pepper.
References
Aboutorabi M (2018) A review on the biological control of plant diseases using various microorganisms. J Res Med Sci 6(4):30–35
Anandaraj M, Sarma YR (1995) Diseases of black pepper (Piper nigrum L.) and their management. J Spices Aromat Crops 4(1):17–23
Anusree T (2019) Diversity and bioactive potential of rhizospheric actinomycetesfom black pepper (Piper nigrum L.). Ph.D. Thesis, Mangalore University
Anusree T, Suseela Bhai R, Ahammed Shabeer TP, Oulkar D (2019) Streptomyces spp from black pepper rhizosphere: a boundless reservoir of antimicrobial and growth promoting metabolites. J Biol Active Prod Nat 9(1):1–23
Benhamou N, Chet I (1997) Cellular and molecular mechanisms involved in the interaction between Trichoderma harzianum and Pythium ultimum. Appl Environ Microbiol 63(5):2095–2099
Bhai RS, Kishore VK, Kumar A, Anandaraj M, Eapen SJ (2005) Screening of rhizobacterial isolates against soft rot disease of ginger (Zingiber officinale Rosc.). J Spices Aromat Crops 14(2):130–136
Bhai RS, Lijina A, Prameela TP, Krishna PB, Anusree T (2016) Biocontrol and growth promotive potential of Streptomyces spp. in black pepper (Piper nigrum L.). J Biol Control 30(3):63–71
Bhai RS, Eapen SJ, Kumar A, Aravind R, Pervez R, Varghese EM, Krishna PB, Sreeja K (2017) Mitigating Phytophthora foot rot and slow decline diseases of black pepper through the deployment of bacterial antagonists. J Spices Aromat Crops 26(2):69–82
Bressan W (2003) Biological control of maize seed pathogenic fungi by use of actinomycetes. Biocontrol 48(2):233–240
Chamberlain K, Crawford DL (1999) In vitro and in vivo antagonism of pathogenic turfgrass fungi by Streptomyces hygroscopicus strains YCED9 and WYE53. J Ind Microbiol Biotechnol 23(1):641–646
Conrath U, Beckers GJ, Langenbach CJ, Jaskiewicz MR (2015) Priming for enhanced defense. Annu Rev Phytopathol 53:97–119
Crawford DL, Lynch JM, Whipps JM, Ousley MA (1993) Isolation and characterization of actinomycete antagonists of a fungal root pathogen. Appl Environ Microbiol 59(11):3899–3905
Doumbou CL, Akimov V, Côté M, Charest PM, Beaulieu C (2001a) Taxonomic study on nonpathogenic streptomycetes isolated from common scab lesions on potato tubers. Syst Appl Microbiol 24(3):451–456
Doumbou CL, Hamby SM, Crawford DL, Beaulieu C (2001b) Actinomycetes, promising tools to control plant diseases and to promote plant growth. Phytoprotection 82(3):85–102
Eapen SJ, Beena B, Ramana KV (2009) Field evaluation of Trichoderma harzianum, Pochonia chlamydosporia and Pasteuria penetrans in a root knot nematode infested black pepper (Piper nigrum L.) garden in India. J Plant Crops 37(3):196–200
Elad Y, Chet I, Katan Y (1980) Trichoderma harzianum a bio control agent effective against Sclerotium rolfsii and Rhizoctonia solani. Phytopathology 70:119–121
El-Mohamedy RSR (2012) Biological control of Pythium root rot of broccoli plants under greenhouse conditions. J Agric Technol 8:1017–1028
Hazarika DK (1998) Biological management of root rot of french bean (Phaseolus vulgaris L.) caused by Rhizoctoniasolani. Plant Dis Res 13:101–105
Heydari A, Pessarakli M (2010) A review on biological control of fungal plant pathogens using microbial antagonists. J Biol Sci 10(4):273–290
Itelima JU, Bang WJ, Onyimba IA, Sila MD, Egbere OJ (2018) Biofertilizers as key player in enhancing soil fertility and crop productivity: a review. J Microbiol Biotechnol Rep 2(1):22–28
Kekuda PTR, Shobha KS, Onkarappa R (2010) Studies on antioxidant and anthelmintic activity of two Streptomyces species isolated from Western Ghat soils of Agumbe, Karnataka. J Pharm Res 3(1):26–29
Khare A, Upadhyay RS (2009) Induction of mutant strains of Trichoderma viride1433 for biocontrol of Pythium aphanidermatum. Environ Biol Conserv 14:21–27
Küçükyumuk Z, Özgönen H, Erdal I, Eraslan F (2014) Effect of zinc and Glomusintraradices on control of Pythium deliense, plant growth parameters and nutrient concentrations of cucumber. Notulae Botanicae Horti Agrobotanici Cluj-Napoca 42(1):138–142
Ligon JM, Hill DS, Hammer PE, Torkewitz NR, Hofmann D, Kempf HJ, Pée KHV (2000) Natural products with antifungal activity from Pseudomonas biocontrol bacteria. Pest Manag Sci Former Pestic Sci 56(8):688–695
Lo CT, Nelson EB, Harman GE (1997) Improved biocontrol efficacy of Trichoderma harzianum 1295–22 for foliar phases of turf diseases by use of spray applications. Plant Dis 81(10):1132–1138
Mukherjee M, Mukherjee PK, Horwitz BA, Zachow C, Berg G, Zeilinger S (2012) Trichoderma–plant–pathogen interactions: advances in genetics of biological control. Indian J Microbiol 52(4):522–529
Muthukumar A, Eswaran A, Sanjeevkumas K (2011) Exploitation of Trichoderma species on the growth of Pythium aphanidermatum in chilli. Braz J Microbiol 42(4):1598–1607
Nygren K, Dubey M, Zapparata A, Iqbal M, Tzelepis GD, Durling MB, Jensen DF, Karlsson M (2018) The mycoparasitic fungus Clonostachys rosea responds with both common and specific gene expression during interspecific interactions with fungal prey. Evol Appl 11(6):931–949
Raaijmakers JM, Vlami M, De Souza JT (2002) Antibiotic production by bacterial biocontrol agents. Antonie Van Leeuwenhoek 81(1–4):537
Ravikumar S, Gnanadesigan M, Saravanan A, Monisha N, Brindha V, Muthumari S (2012) Antagonistic properties of seagrass associated Streptomyces sp. RAVACT-1: a source of anthraquinone rich compound. Asian Pac J Trop Med 5(11):887–890
Reithner B, Ibarra-Laclette E, Mach RL, Herrera-Estrella A (2011) Identification of mycoparasitism-related genes in Trichoderma atroviride. Appl Environ Microbiol 77(13):4361–4370
Subila KP, Suseela Bhai R (2020) Pythium deliense, a pathogen causing yellowing and wilt of black pepper in India. New Disease Rep 42:6. https://doi.org/10.5197/j.2044-0588.2020.042.006
Thampi A, Bhai RS (2017) Rhizosphere actinobacteria for combating Phytophthora capsici and Sclerotium rolfsi, the major soil borne pathogens of black pepper (Piper nigrum L.). Biol Control 109:1–13. https://doi.org/10.1016/j.biocontrol.2017.03.006
Tokala RK, Strap JL, Jung CM, Crawford DL, Salove MH, Deobald LA, Bailey JF, Morra MJ (2002) Novel plant-microbe rhizosphere interaction involving Streptomyces lydicus WYEC108 and the pea plant (Pisum sativum). Appl Environ Microbiol 68(5):2161–2171
Trejo-Estrada SR, Paszczynski A, Crawford DL (1998) Antibiotics and enzymes produced by the biocontrol agent Streptomyces violaceusnigerYCED-9. J Ind Microbiol Biotechnol 21(1–2):81–90
Truong NV, Burgess LW, Liew EC (2005) Survey of quick wilt of black pepper in Vietnam. In: The 15th biennial Australasian Plant Pathology Society conference handbook. Australasian Plant Pathology Society, pp 376
Vandana VV, Suseela Bhai R, Azeez S (2014) Biochemical defense responses of black pepper (Piper nigrum L.) lines to Phytophthora capsici. Physiol Mol Plant Pathol 88:18–27
Vincent JM (1947) Distortion of fungal hyphae in the presence of certain inhibitors. Nature 159(4051):850–850
Weindling R (1934) Studies on a lethal principle effective in the parasitic action of Trichoderma lignorum on Rhizoctonia solani and other soil fungi. Phytopathology 24(1):153–151
Weller DM (1988) Biological control of soilborne plant pathogens in the rhizosphere with bacteria. Annu Rev Phytopathol 26(1):379–407
Yuan WM, Crawford DL (1995) Characterization of Streptomyces lydicus WYEC108 as a potential biocontrol agent against fungal root and seed rots. Appl Environ Microbiol 61(8):3119–3128
Acknowledgements
The authors express their sincere thanks to Mr. N.O. Varkey, Ambalavayal, Wayanad, Kerala for permitting to carry out this experiment in his black pepper field, and his support and cooperation during the period was duly acknowledged. The authors are grateful to Director, ICAR-IISR for the facilities and Mr. K. Jayarajan for statistical analysis.
Funding
Not applicable.
Author information
Authors and Affiliations
Corresponding authors
Ethics declarations
Conflict of interest
The authors declare that they have no known competing financial interests or personal relationships that could have appeared to influence the work reported in this paper.
Ethical approval
This article does not contain any studies with human participants or animals performed by any of the authors.
Additional information
Communicated by Erko Stackebrandt.
Publisher's Note
Springer Nature remains neutral with regard to jurisdictional claims in published maps and institutional affiliations.
Rights and permissions
About this article
Cite this article
Kizhakke Purayil, S., Bhai, R.S. Efficacy of bioagents against Pythium deliense Meurs associated with yellowing of black pepper. Arch Microbiol 203, 2597–2604 (2021). https://doi.org/10.1007/s00203-021-02252-3
Received:
Revised:
Accepted:
Published:
Issue Date:
DOI: https://doi.org/10.1007/s00203-021-02252-3